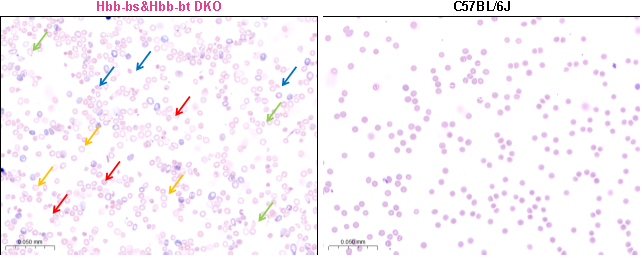

β地中海贫血(β-thalassemia)是一种由血红蛋白β链(β-globin)合成减少或缺失引起的遗传性血液疾病,是WHO关注的全球社会公共问题之一[1]。
HBB基因突变致病
血红蛋白(Hemoglobin, Hb)是红细胞中负责将氧气输送到全身的蛋白质,其结构主要由两个α-globin亚基和两个β-globin亚基组成。每个亚基都包含一个血红蛋白分子中心的血红素(Heme)分子,血红素可结合一个铁离子,使血红蛋白具有携氧的能力。
在正常成年人体内,β-globin链由HBB基因编码。两条β-globin链与两条α-globin链(由HBA1基因或HBA2基因编码)构成的成人血红蛋白(HbA)约占总血红蛋白的97%[2]。β地中海贫血患者HBB基因突变造成β-globin链合成减少或缺失,导致血红蛋白水平较低并引起红细胞生成障碍、红细胞过早破坏和贫血等症状。
β地中海贫血的临床类型
由导致β-globin链生成完全缺失的突变造成的地中海贫血称为β0地中海贫血,而由β-globin链生成部分受抑制的突变导致的则称为β+地中海贫血[3]。
重型β地中海贫血患者携带β0或β+地中海贫血纯合突变或β0与β+地中海贫血双重杂合突变,β-globin链生成完全或几乎完全缺失,以致含有β-globin链的HbA合成减少或消失。β-globin链的缺失造成α-globin链与非α-globin链合成比例不平衡,导致α-globin链相对过剩并在红细胞内形成包涵体,导致红细胞膜的氧化损伤,造成红细胞破坏及骨髓无效造血。
轻型β地中海贫血患者携带β0或β+地中海贫血杂合突变,β-globin链合成轻度减少,其病理症状较轻。
中间型β地中海贫血患者携带某些β+地中海贫血双重杂合突变和某些异型地中海贫血纯合突变,或两种不同变异型珠蛋白生成障碍性贫血突变的双重杂合状态,其病理生理改变介于重型和轻型之间[4]。
Hbb基因编辑模型构建
C57BL/6小鼠存在Hbb-bs和Hbb-bt两个高度相似的成年β-globin蛋白编码基因,这两个基因位于小鼠7号染色体上的相邻位置且都包含3个外显子[5-6]。Hbb-bs&Hbb-bt DKO小鼠是利用基因编辑技术同时敲除C57BL/6J小鼠Hbb-bs基因和Hbb-bt基因所构建的β地中海贫血疾病模型。该模型纯合致死,杂合小鼠呈现血红蛋白含量、红细胞计数、红细胞压积、平均红细胞血红蛋白浓度、红细胞分布宽度、血小板数、脾脏大小和红细胞形态等指标异常的严重地中海贫血典型特征并具有生育能力。因此,杂合Hbb-bs&Hbb-bt DKO小鼠可用于与β地中海贫血相关的研究。
Hbb-bs&Hbb-bt DKO模型验证数据
(1)生长曲线

图1 杂合Hbb-bs&Hbb-bt DKO小鼠和野生型(WT)小鼠的体重变化曲线,雌性和雄性杂合Hbb-bs&Hbb-bt DKO小鼠均呈现和野生型小鼠较为一致的生长状况。
(2) 生存曲线

图2 杂合Hbb-bs&Hbb-bt DKO小鼠和野生型(WT)小鼠的生存曲线,雄性杂合Hbb-bs&Hbb-bt DKO小鼠在第13周开始出现死亡情况,雌性杂合Hbb-bs&Hbb-bt DKO小鼠在第15周开始出现死亡情况。
(3) 血常规检测

图3 14周龄雄性杂合Hbb-bs&Hbb-bt DKO小鼠和野生型(WT)小鼠血常规检测
血常规检测结果表明,与野生型小鼠相比,杂合Hbb-bs&Hbb-bt DKO小鼠的红细胞计数(RBC)、血红蛋白含量(HGB)和红细胞压积(HCT)显著下降,平均红细胞血红蛋白浓度(MCHC)略有下降,而红细胞分布宽度(RDW)和血小板计数(PLT)明显上升。这些参数变化与相似基因突变类型导致的β地中海贫血临床表型相似。
(4)血涂片分析
图4 14周龄雄性杂合Hbb-bs&Hbb-bt DKO小鼠和C57BL/J野生型小鼠血涂片检测分析
血涂片分析结果显示杂合Hbb-bs&Hbb-bt DKO小鼠有核细胞数占比增加,红细胞中央浅染区扩大且出现较多异形、碎片红细胞和有核红细胞。其外周血中存在靶形红细胞(黄色箭头)、棘形状红细胞(红色箭头)、泪滴状红细胞(绿色箭头)和破碎状红细胞(蓝色箭头)等多种异常形态红细胞。C57BL/J野生型小鼠红细胞形态结构完整,呈现双凹圆盘状且未见明显异常。
参考文献:
[1]Galanello R, Origa R. Beta-thalassemia. Orphanet J Rare Dis. 2010 May 21;5:11.
[2]Hardison RC. Evolution of hemoglobin and its genes. Cold Spring Harb Perspect Med. 2012 Dec 1;2(12):a011627.
[3]Thein SL. Molecular basis of β thalassemia and potential therapeutic targets. Blood Cells Mol Dis. 2018 May;70:54-65.
[4]Origa R. β-Thalassemia. Genet Med. 2017 Jun;19(6):609-619.
[5]Zhang F, Zhang B, Wang Y, Jiang R, Liu J, Wei Y, Gao X, Zhu Y, Wang X, Sun M, Kang J, Liu Y, You G, Wei D, Xin J, Bao J, Wang M, Gu Y, Wang Z, Ye J, Guo S, Huang H, Sun Q. An extra-erythrocyte role of haemoglobin body in chondrocyte hypoxia adaption. Nature. 2023 Oct;622(7984):834-841.
[6]Trimborn T, Gribnau J, Grosveld F, Fraser P. Mechanisms of developmental control of transcription in the murine alpha- and beta-globin loci. Genes Dev. 1999 Jan 1;13(1):112-24.



